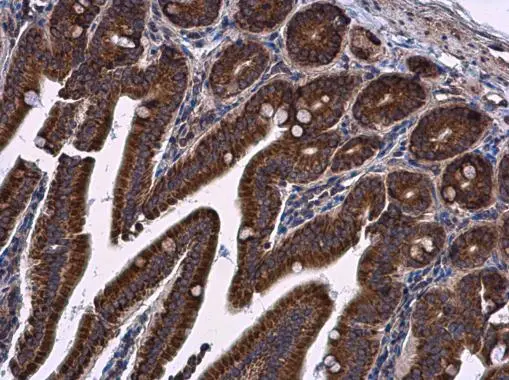
LRRC59 antibody detects LRRC59 protein at cytoplasm in mouse duodenum by immunohistochemical analysis. Sample: Paraffin-embedded mouse duodenum. LRRC59 antibody (GTX122902) diluted at 1:500.
Antigen Retrieval: Citrate buffer, pH 6.0, 15 min LRRC59 antibody detects LRRC59 protein at cytoplasm in mouse duodenum by immunohistochemical analysis. Sample: Paraffin-embedded mouse duodenum. LRRC59 antibody (GTX122902) diluted at 1:500.
Antigen Retrieval: Citrate buffer, pH 6.0, 15 min

Wild-type (WT) and LRRC59 knockout (KO) 293T cell extracts (30 μg) were separated by 12% SDS-PAGE, and the membrane was blotted with LRRC59 antibody (GTX122902) diluted at 1:1000. The HRP-conjugated anti-rabbit IgG antibody (GTX213110-01) was used to detect the primary antibody.
LRRC59 antibody
GTX122902
ApplicationsImmunoFluorescence, Western Blot, ImmunoCytoChemistry, ImmunoHistoChemistry, ImmunoHistoChemistry Paraffin
Product group Antibodies
ReactivityHuman, Mouse
TargetLRRC59
Overview
- SupplierGeneTex
- Product NameLRRC59 antibody
- Delivery Days Customer9
- Application Supplier NoteWB: 1:500-1:3000. ICC/IF: 1:100-1:1000. IHC-P: 1:100-1:1000. *Optimal dilutions/concentrations should be determined by the researcher.Not tested in other applications.
- ApplicationsImmunoFluorescence, Western Blot, ImmunoCytoChemistry, ImmunoHistoChemistry, ImmunoHistoChemistry Paraffin
- CertificationResearch Use Only
- ClonalityPolyclonal
- Concentration1 mg/ml
- ConjugateUnconjugated
- Gene ID55379
- Target nameLRRC59
- Target descriptionleucine rich repeat containing 59
- Target synonymsPRO1855, p34, leucine-rich repeat-containing protein 59, ribosome-binding protein p34
- HostRabbit
- IsotypeIgG
- Protein IDQ96AG4
- Protein NameLeucine-rich repeat-containing protein 59
- ReactivityHuman, Mouse
- Storage Instruction-20°C or -80°C,2°C to 8°C
- UNSPSC41116161